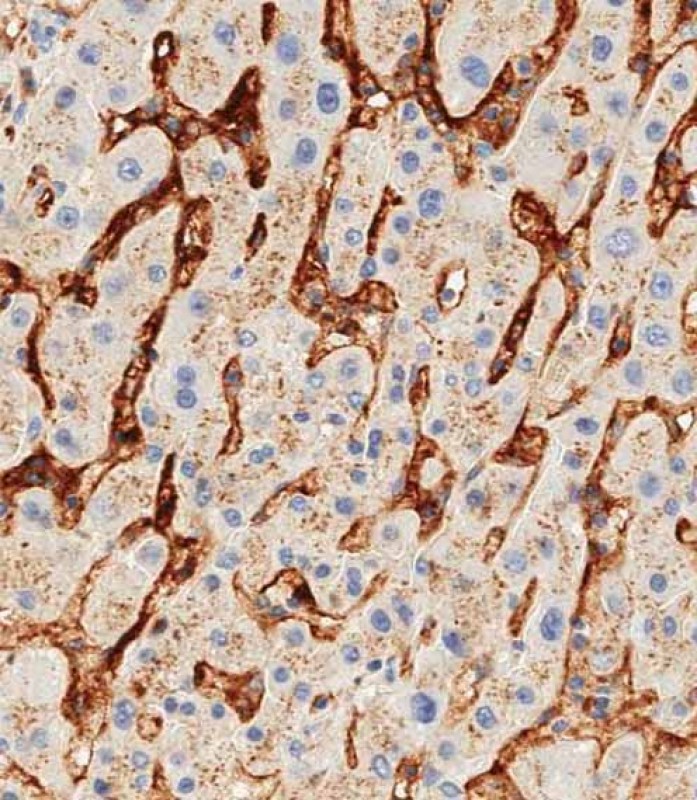

CD14 Antibody (N-term)
Purified Rabbit Polyclonal Antibody (Pab)
- 产品详情
- 文献引用 : 4
- 实验流程
- 背景知识
Application
| IHC-P, WB, FC, IF, IHC-P-Leica, E |
|---|---|
| Primary Accession | P08571 |
| Reactivity | Human |
| Host | Rabbit |
| Clonality | Polyclonal |
| Isotype | Rabbit IgG |
| Calculated MW | 40076 Da |
| Antigen Region | 54-83 aa |
| Gene ID | 929 |
|---|---|
| Other Names | Monocyte differentiation antigen CD14, Myeloid cell-specific leucine-rich glycoprotein, CD14, Monocyte differentiation antigen CD14, urinary form, Monocyte differentiation antigen CD14, membrane-bound form, CD14 |
| Target/Specificity | This CD14 antibody is generated from rabbits immunized with a KLH conjugated synthetic peptide between 54-83 amino acids from the N-terminal region of human CD14. |
| Dilution | IHC-P~~1:100~500 WB~~1:2000 FC~~1:10~50 IF~~1:10~50 IHC-P-Leica~~1:1000 E~~Use at an assay dependent concentration. |
| Format | Purified polyclonal antibody supplied in PBS with 0.09% (W/V) sodium azide. This antibody is purified through a protein A column, followed by peptide affinity purification. |
| Storage | Maintain refrigerated at 2-8°C for up to 2 weeks. For long term storage store at -20°C in small aliquots to prevent freeze-thaw cycles. |
| Precautions | CD14 Antibody (N-term) is for research use only and not for use in diagnostic or therapeutic procedures. |
| Name | CD14 |
|---|---|
| Function | Coreceptor for bacterial lipopolysaccharide (PubMed:1698311, PubMed:23264655). In concert with LBP, binds to monomeric lipopolysaccharide and delivers it to the LY96/TLR4 complex, thereby mediating the innate immune response to bacterial lipopolysaccharide (LPS) (PubMed:20133493, PubMed:22265692, PubMed:23264655). Acts via MyD88, TIRAP and TRAF6, leading to NF-kappa-B activation, cytokine secretion and the inflammatory response (PubMed:8612135). Acts as a coreceptor for TLR2:TLR6 heterodimer in response to diacylated lipopeptides and for TLR2:TLR1 heterodimer in response to triacylated lipopeptides, these clusters trigger signaling from the cell surface and subsequently are targeted to the Golgi in a lipid-raft dependent pathway (PubMed:16880211). Binds electronegative LDL (LDL(-)) and mediates the cytokine release induced by LDL(-) (PubMed:23880187). |
| Cellular Location | Cell membrane; Lipid-anchor, GPI-anchor. Secreted. Membrane raft. Golgi apparatus. Note=Secreted forms may arise by cleavage of the GPI anchor. |
| Tissue Location | Detected on macrophages (at protein level) (PubMed:1698311). Expressed strongly on the surface of monocytes and weakly on the surface of granulocytes; also expressed by most tissue macrophages. |
For Research Use Only. Not For Use In Diagnostic Procedures.

Provided below are standard protocols that you may find useful for product applications.
BACKGROUND
CD14 is a surface protein preferentially expressed on monocytes/macrophages. It binds lipopolysaccharide binding protein and recently has been shown to bind apoptotic cells.
REFERENCES
Donati,M., J. Periodontol. 79 (3), 517-524 (2008)
Yuan,F.F., Immunol. Cell Biol. 86 (3), 268-270 (2008)
Setoguchi,M., Biochim. Biophys. Acta 1008 (2), 213-222 (1989)
Goyert,S.M., Science 239 (4839), 497-500 (1988)
终于等到您。ABCEPTA(百远生物)抗体产品。
点击下方“我要评价 ”按钮提交您的反馈信息,您的反馈和评价是我们最宝贵的财富之一,
我们将在1-3个工作日内处理您的反馈信息。
如有疑问,联系:0512-88856768 tech-china@abcepta.com.






















 癌症的基本特征包括细胞增殖、血管生成、迁移、凋亡逃避机制和细胞永生等。找到癌症发生过程中这些通路的关键标记物和对应的抗体用于检测至关重要。
癌症的基本特征包括细胞增殖、血管生成、迁移、凋亡逃避机制和细胞永生等。找到癌症发生过程中这些通路的关键标记物和对应的抗体用于检测至关重要。 为您推荐一个泛素化位点预测神器——泛素化分析工具,可以为您的蛋白的泛素化位点作出预测和评分。
为您推荐一个泛素化位点预测神器——泛素化分析工具,可以为您的蛋白的泛素化位点作出预测和评分。 细胞自噬受体图形绘图工具为你的蛋白的细胞受体结合位点作出预测和评分,识别结合到自噬通路中的蛋白是非常重要的,便于让我们理解自噬在正常生理、病理过程中的作用,如发育、细胞分化、神经退化性疾病、压力条件下、感染和癌症。
细胞自噬受体图形绘图工具为你的蛋白的细胞受体结合位点作出预测和评分,识别结合到自噬通路中的蛋白是非常重要的,便于让我们理解自噬在正常生理、病理过程中的作用,如发育、细胞分化、神经退化性疾病、压力条件下、感染和癌症。